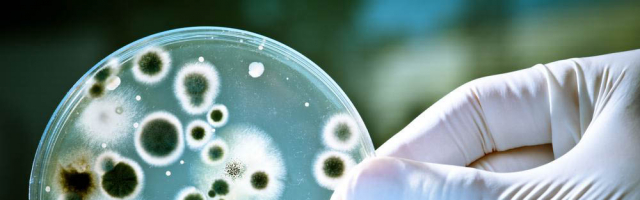

Цены на золото и серебро продолжают бить рекорды

Серебро достигло самого высокого уровня за десятилетие.
Антибиотики теряют силу, «бактерии-мутанты» погубят человечество
Человечество может столкнуться с самой опасной «тихой пандемией» — устойчивостью бактерий к лечению.






